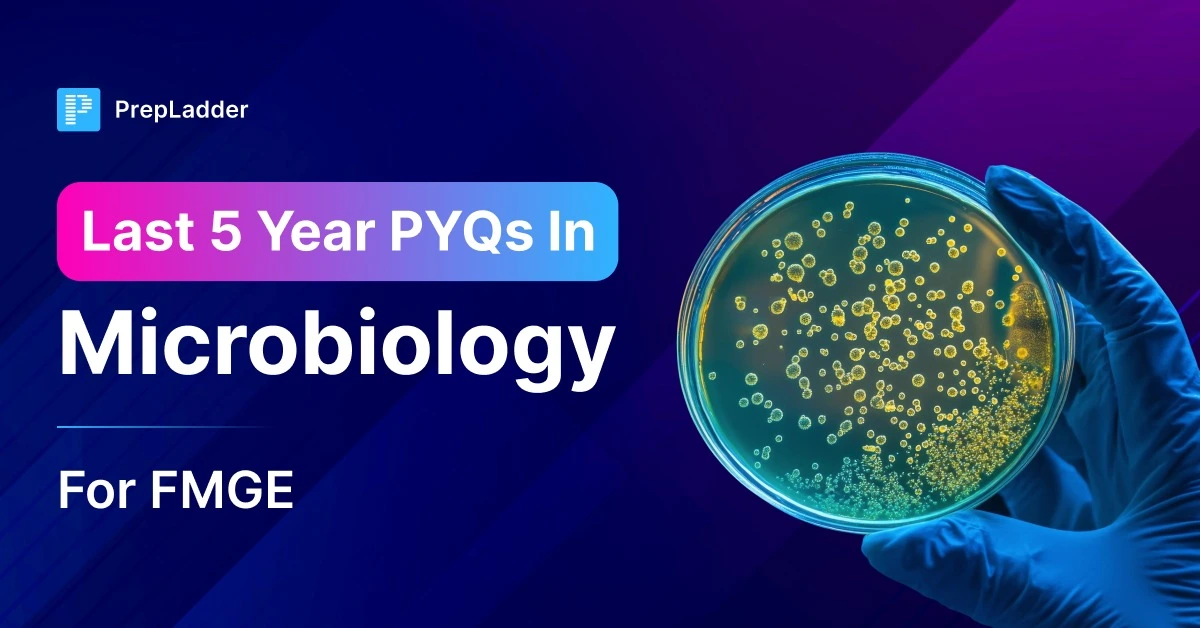
img

Explore our high yield content
Last 5 Year PYQs in Microbiology for FMGE
When it comes to preparing for FMGE, there is no smarter way to understand exam patterns, identify high-yield topics, and refine your strategy th...Read MoreJan 07 2026
Virology Insights: Facts on Herpes, Hepatitis, and Viral Infections
Classification of HerpesviridaeHHV1 - Human Herpes Simplex Virus 1HHV2 - Huan Herpes Simplex Virus 2HHV3 - Human Herpes Zoster VirusHHV4 - HumanRead MoreNov 30 2024
Understanding Microbial Staining and Sterilization Methods
Chanting LinesGram StainingPrimary stain is crystal violet.Iodine (Mordant) is a fixer.Safranin is a secondary stain.Gram+ve organisms are purple...Read MoreNov 26 2024
Antimicrobial Drugs: Combatting Infections
Antimicrobial drugs are the agents that kills microorganisms or prevent their growth in the body. There are different kinds of antibacterial medi...Read MoreMay 08 2024